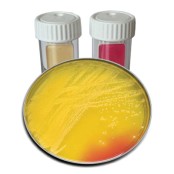

- Produkte
-
Produkte
- Labor
-
Geräte für die Diagnostik
- Amblyopiescreener & Sehtestgeräte
- Audiometer
- Blutanalyse-Geräte
- Blutdruckmessgeräte
- Dermatoskope
- EEG
- EKG
- Ergometer
- Fetalmonitore CTG
- Gefäßdoppler
- Gerinnungsmessgeräte
- Größen- & Umfangmesser
- Harnteststreifen-Lesegeräte
- Kapnometer
- OAE Screener
- Otoskope & Ophthalmoskope
- Pulsoximeter
- Sehtesttafeln
- Spirometer
- Stethoskope
- Thermometer
- Tympanometer
- Vitalmonitore & Patientenmonitore
- Waagen
- Geräte für die Therapie
- Katheter, Stents und Inkontinenz
- Verbrauchsmaterial und Praxisbedarf
- Instrumente
- Hygiene & Aufbereitung
- Erste Hilfe, Notfallausstattung
- Patientenmanagement
- Kinderwunsch
- Personal Healthcare / Gesundes Leben
- Dental
- Software-Lösungen
- Serviceangebot
- Mehr Details: Produkte
- Technischer Service
- Leihgeräte
- Serviceangebot
- Über uns
- Aktuelles
- FAQ
- Kontakt